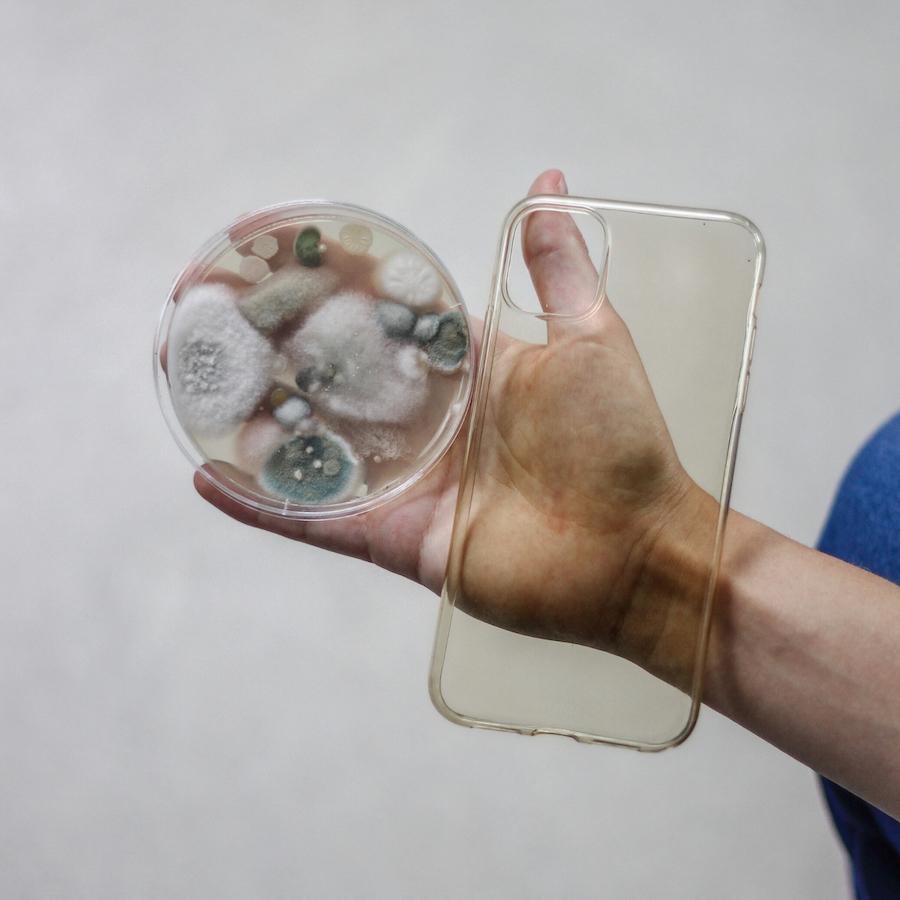

Részletek:
Futamidő:
hónapVásárlás összege:
Ft
Válassz futamidőt:
Önrész összege Ft
A kiválasztott konstrukció az egyéni kalkuláció alapján
Részletek
A világ legtisztább okostelefon tokja
Woodcessories védi a bolygót és Téged! Szalmából és búzából készült új biológiailag lebomló Bio tokunk eltávolítja a telefon összes baktériumának akár 99,99% -át! Növényi maradványokból készült borítónkkal tökéletes környezetbarát és tisztességes alternatívát kínálunk! A világ legtisztább okostelefon tokja

Tudtad, hogy a telefonodon több baktérium lapul meg mint gondolnád?
A higiénia minden eddiginél fontosabb, és a rendszeres kézmosás és fertőtlenítés ma már a mindennapjaink része. De gondolt-e valaha azokra a dolgokra, amelyeket nap mint nap magunkkal cipelünk? Egy ember naponta körülbelül 100 alkalommal veszi fel az okostelefonját, és számtalan felületre teszi. Gyakran több baktérium található rajta, mint egy WC-csészén!
A baktériumok és kórokozók gyakran több napig is megmaradnak a készüléken, és egy gyors törlés a pólón nem sokat segít. Hisszük, hogy valaminek, amihez gyakran hozzáérünk a kezünkkel és az arcunkkal, a lehető legtisztábbnak és higiénikusabbnak kell lennie.

A Bio tokunk a megoldás!
Több hónapon keresztül együttműködtünk különböző tesztlaboratóriumokkal és beszállítókkal az új higiénikus Bio tokunk kifejlesztésében, amely tartós antimikrobiális anyagot tartalmaz, hogy garantáltan elpusztítsa az összes veszélyes baktériumot!

Önfertőtlenítő és higiénikusan tiszta!
A baktériumok szabad szemmel nem láthatók, de mindig veled vannak. Tanulmányok kimutatták, hogy különösen okostelefonjainkon több ezer olyan baktérium van, amely káros lehet az egészségére. Természetesen ezt meg akarjuk akadályozni, és hosszú heteken át teszteltük a különböző anyagokat, hogy a Bio tok készülékünk nemcsak fenntartható, hanem higiénikus és öntisztító is legyen!





